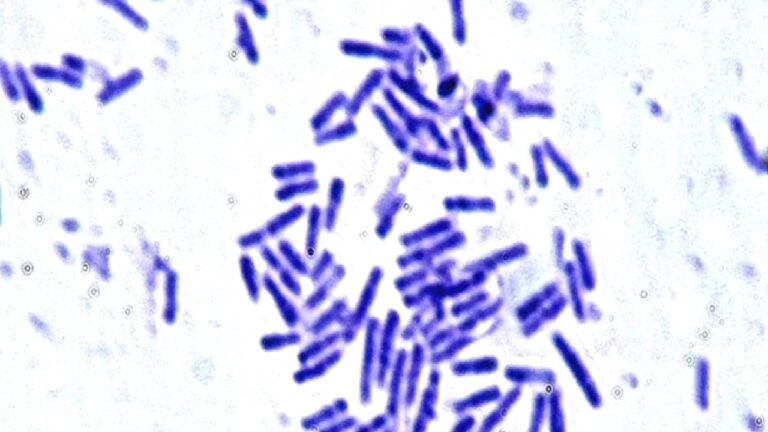
Astronotlar için umut veren keşif: Mikroorganizmaların uzay direnci kanıtlandı

Astronotlar için umut veren keşif: Mikroorganizmaların uzay direnci kanıtlandı
Gelecekteki uzun süreli Ay veya Mars görevlerinde astronotların sağlığını korumak için en büyük zorluklardan biri, vücutlarındaki hayati mikroorganizmaların uzay koşullarına dayanıp dayanamayacağıydı. Avustralyalı bilim insanları, bu bakterileri uzaya gönderdi ve gelen sonuç şaşırtıcı oldu.
İnsan sağlığının temel direği olan mikroorganizmalar, yalnızca Dünya’da değil, uzay yolculuğunun aşırı zorlu koşullarında da şaşırtıcı bir direnç gösteriyor. Avustralya’daki Royal Melbourne Institute of Technology (RMIT) Üniversitesi’nden araştırmacıların yaptığı deney, bu hayati mikropların, uzun süreli uzay görevlerinde astronotların sağlığını koruma konusunda ne denli kritik bir rol oynayabileceğini gözler önüne serdi.
RMIT’li bilim insanları, insan bağışıklık sistemini destekleyen ve sindirime yardımcı olan Bacillus subtilis (B. subtilis) bakterisinin sporlarını, özel olarak üç boyutlu yazıcıyla üretilmiş mikro tüp taşıyıcılar içinde uzaya gönderdi. Deneyin amacı, bu bakterilerin fırlatma sırasındaki muazzam ivmelenme, mikro yerçekimi ve Dünya’ya geri girişin sarsıntılı koşullarına nasıl tepki verdiğini anlamaktı.
Gelecekte Mars’ta kurulacak kalıcı bir kolonide, B. subtilis gibi faydalı bakterilerin insan yaşamını sürdürmede hayati bir rol oynayacağı düşünülüyor. Astronotların sindirim, bağışıklık ve genel sağlık dengesini koruyabilmesi için sağlıklı bir mikrobiyoma sahip olmaları gerekiyor ve bu mikropların uzay yolculuğunun en zorlu geçiş evrelerinden sağ çıkabilmesi, Ay’a, Mars’a ve daha uzaklara güvenle taşınabileceği anlamına geliyor.
13 G’lik çekime ve 30 G’lik yavaşlamaya kafa tuttular
Deney sırasında mikroorganizmalar, normal şartlarda hayal bile edilemeyecek fiziksel streslere maruz bırakıldı: Dünya’nın çekim gücünün 13 katına kadar çıkan ivmelenme kuvvetleri, yaklaşık 162 kilometre yükseklikte 6 dakikalık ağırlıksızlık, saniyede 220 kez dönerek 30 g’ye kadar çıkan yavaşlama kuvvetleri…
Roketin inişinin ardından yapılan analizler, bilim insanlarını şaşırttı. Bakterilerin yapısında herhangi bir bozulma görülmediği gibi, sporların Dünya’daki gibi normal bir şekilde büyümeye devam ettiği belirlendi.
RMIT Üniversitesi’nden Prof. Elena Ivanova, bu bulguların önemini vurgulayarak, bakterinin hızlı yerçekimi değişimlerine, fırlatma ivmesine ve iniş yavaşlamasına karşı olan olağanüstü dayanıklılığının kanıtlandığını belirtti. Bu sonuç, uzun süreli uzay yolculuklarının mikroorganizmalar üzerindeki etkisini anlamamıza büyük katkı sağlıyor ve astronotlar için daha gelişmiş yaşam destek sistemleri tasarlamamızın yolunu açıyor.
Bu çalışma, bakterilerin laboratuvar ortamı dışında, gerçek bir uzay uçuşu sırasında fırlatmadan inişe kadar tüm aşırı fiziksel streslere nasıl tepki verdiğini doğrudan test etmesi bakımından benzersiz kabul ediliyor. Daha önce Uluslararası Uzay İstasyonu’nda yapılan deneylerde bakterilerin radyasyona ve havasız ortama dayanıklılığı görülmüştü, ancak bu yeni test, fırlatma ve inişin bütünsel etkisini ortaya koydu.
Araştırma, npj Microgravity dergisinde 6 Ekim tarihinde yayımlandı.









